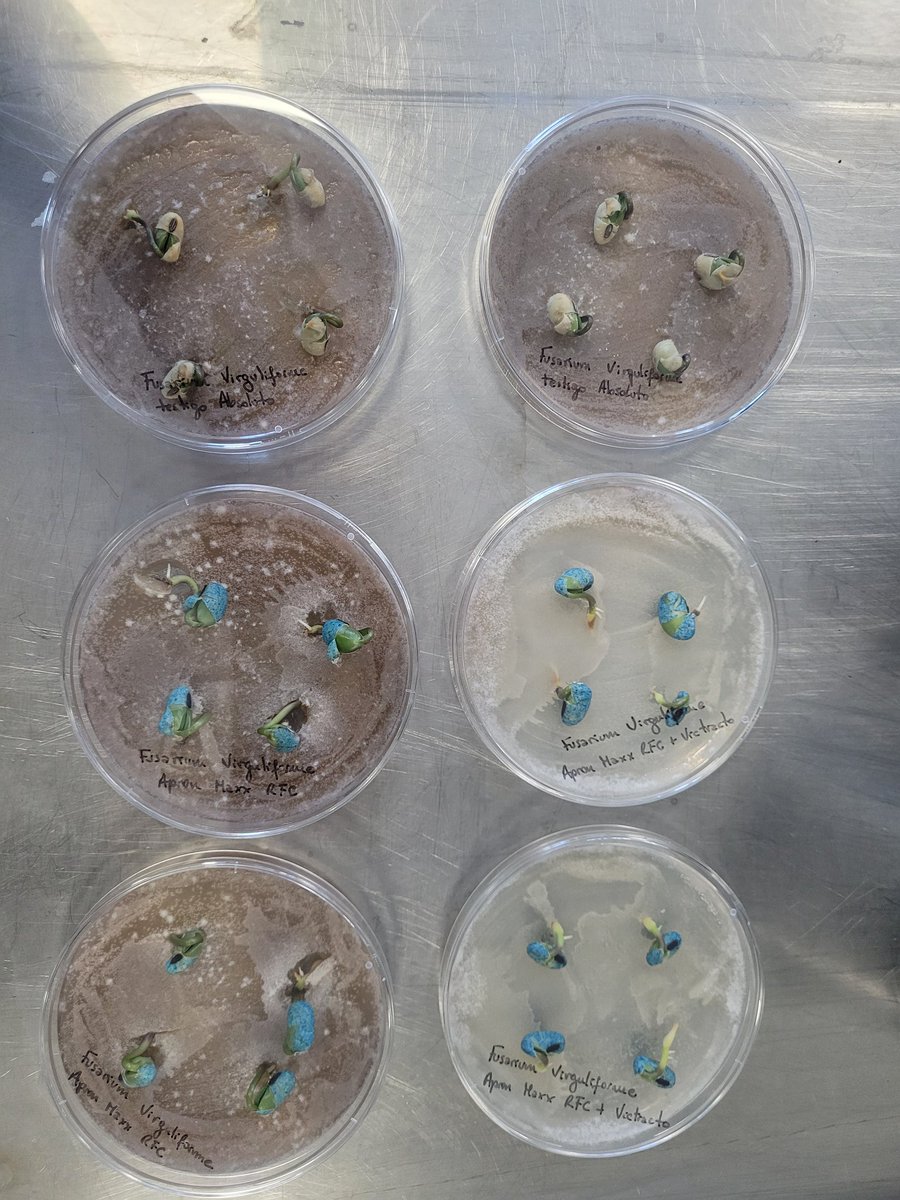
pablo mainez 🐃 tweet media

Natalia Schmithalter
106 posts

Natalia Schmithalter
@Natyschmith
Ing. Agr. MP 1082 Servicio Técnico Noroeste de Santa fe, Syngenta.
Rafaela, Argentina Katılım Nisan 2022
1.1K Takip Edilen836 Takipçiler
Natalia Schmithalter retweetledi

La problemática de Chicharrita - Dalbulus sigue dando que hablar. Entendimos la plaga, esperamos las heladas y nos preparanos Sin temores para la próxima de #MAIZ de primera. Esta vez sumamos al manejo de la plaga los monitoreos y seguimientos con #cropwise.
#EnElCampoConSyngenta




Español
Natalia Schmithalter retweetledi

#Agua2m #SEPA_INTA @intaargentina
Así habría empezado la semana con 🌧 q estamos transitando💪🏽
Completaría recarga en varias zonas, y hasta algo #NapaCera
Aumentaría el área apta para doble cultivo💪🏽
MIDAN #Agua2m y DECIDAN🧐
#AgroAdaptativo 🔵🟢🔴

Jorge Mercau 🇦🇷@JorgeLMercau
Cuándo y cuánto llovería🌧️ @intaargentina #ClimayAgua @INTARNaturales
Español
Natalia Schmithalter retweetledi

Sojineta @Syngenta_ar en el NOA! reunión en Anta-Salta, con clientes y técnicos amigos, en NECA. Época de definiciones para el manejo foliar de EFC (mancha anillada,MOR, Septoria)..."#Miravis duo"
#EnElCampoConSyngenta


Español
Natalia Schmithalter retweetledi

Cerramos una semana de gira pasando x Rufino, Venado tuerto, Bustinza, C Pellegrini , Victoria y Urdinarrain.
Discutimos con clientes y especialistas la actualidad de la campaña y las alternativas de manejo. Pronto sigue #LaSojineta
#EnElCampoConSyngenta
@Syngenta_ar
Gálvez, Argentina 🇦🇷 Español

@NRanure @dallorso_juan @Nachoimhoff @S_Lopez89 @Sergio1963Luis @Chaveta4 Muy buena la sojineta! Y todo lo compartido por los especialistas como German Schlie y Caco dall orso.
Español
Natalia Schmithalter retweetledi

Arrancamos con La Sojineta en Rufino, espacio para afinar la toma de decisión en soja junto a técnicos, productores y amigos. Seguimos por la tarde en Venado Tuerto, gracias Herman Schlie, Mauri Durany y @dallorso_juan por acompañarnos. MAÑANA 📍Bustinza y 📍Carlos Pellegrini…


Español
Natalia Schmithalter retweetledi

Cerramos el jueves con un lindo intercambio con @Syngenta_ar y @MartinGalli77


Rafaela, Argentina 🇦🇷 Español
Natalia Schmithalter retweetledi

Si la campaña pasada viste este síntoma (muerte súbita) en tus lotes de soja es pq alguno de estos amiguitos de las cajas de petri te están causando daño, por eso es que @Syngenta_ar lanza.#victrato el primer prod para control de muerte súbita en soja.

Español

@Emilio_Martini1 @Syngenta_ar @JuanpiCileiro Nos vemos en la evaluación a campo sobre la calidad de aplicación de las dos tecnologías @JuanpiCileiro @Emilio_Martini1 🧪🌨️🌿
Español
Natalia Schmithalter retweetledi

#Gaviglio junto a @Syngenta_ar de la mano de @Tino_DeRossi @Natyschmith con productores y asesores de la Zona de #SanFrancisco Manejo Sanitario del cultivo de Maíz en este año "Niña"


San Justo, Argentina 🇦🇷 Español

@Franco_herranz Como lo conseguimos? Los aplaudo. 🙌
Rafaela, Argentina 🇦🇷 Español

Un placer y orgullo haber formado parte de este proyecto. Con dedicación, esfuerzo y el soporte incondicional del Dr. Eduardo Puricelli, tenemos para ofrecer el libro de Mecanismos de Acción de #Fungicidas.

Español

Monitoreando #maices 🌽de siembras de diciembre en V 8, Aparicion de las primeras lesiones de #roya y primeros sintomas de #helmithosporium
#Sacanta #gaviglio junto a
@Syngenta_ar @Syngenta (nuestro ensayo con #amistarxtra en breve 🙌)




Rafaela, Argentina 🇦🇷 Español
Natalia Schmithalter retweetledi

Capacitación técnica @Syngenta_ar con @MartinGalli77 sobre el manejo de plagas junto a @grafer_srl Suardi. Capacitar a clientes es fundamental para lograr un manejo sustentable de los cultivos con nuestros productos @LuisLopezLima2 @WTeloni @DiegoZilli6 @Natyschmith @Gennarus1


Comandante Fernández, Argentina 🇦🇷 Español

@Syngenta_ar Cuantos conocimientos nos compartio esta semana en el manejo de plagas @MartinGalli77 @AAPPCE por mas charlas juntos 🐛🌱🙌
#San guillermo.
Rafaela, Argentina 🇦🇷 Español
Natalia Schmithalter retweetledi

¿Sabés qué es #Virantra?
👉 Es un insecticida que viene a revolucionar el control de insectos.
👉 En un solo producto encontrás la protección ante las principales plagas en cultivos de soja.
Conocé el resto de sus cualidades acá ➡️ youtu.be/9TEuu58Q2Kg

YouTube
Español

Muy buenas jornadas de intercambio en el manejo de insectos 🐛🌱 por este tremendo especialista @MartinGalli77 junto al distribuidor
#gaviglio Lopez y Carlos pellegrini.
@CristianCalcat4 @alejandro_rossa @EmanuelECordoba @AAPPCE @Syngenta_ar
#virantra #miravisduo




Rafaela, Argentina 🇦🇷 Español
Natalia Schmithalter retweetledi

Firme como cada año la Red de Maíz tardío de @aapresid generando información para los productores. Año difícil, todo dato suma! seguimos en campaña. #juntossabemosmás 🌽🌱 Gracias @Celezenklusen por las fotos y Regional Rafaela.


Balcarce, Argentina 🇦🇷 Español



